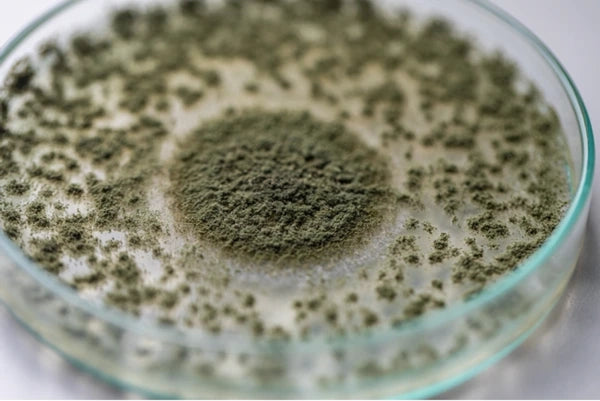
Glucoamylase

Why Your Customers Will Love Supergreen Essentials!
Key Ingredients

Vitamin A (as retinyl palmitate)
Vitamin A is a fat-soluble nutrient that plays a vital role in maintaining vision, supporting skin health, and encouraging immune function. As retinyl palmitate, it is a stable form that is easily absorbed by the body. Vitamin A is essential for cell growth and development and contributes to overall wellness.
Vitamin C (as ascorbic acid)
Vitamin C, as ascorbic acid, is a powerful antioxidant that supports cellular health, immune defense, and skin vitality. It’s essential for collagen production, wound healing, and iron absorption. Since the body can’t produce Vitamin C, regular intake through diet or supplements is necessary.
Vitamin D (as cholecalciferol)
Vitamin D, known as the "sunshine vitamin," helps the body absorb calcium and phosphorus—key for strong bones and teeth. As cholecalciferol (Vitamin D3), it’s the most effective form for raising and maintaining healthy vitamin D levels in the body. It also supports mood, immunity, and muscle function.
Vitamin E (as dl-alpha tocopheryl acetate)
Vitamin E is a powerful antioxidant that helps protect cells from oxidative stress and supports overall immune health. In its dl-alpha tocopheryl acetate form, it offers a stable and effective source of this essential nutrient, promoting skin health, cardiovascular function, and general well-being.
Vitamin K (as phytonadione)
Vitamin K, in the form of phytonadione (Vitamin K1), plays a critical role in blood clotting and bone health. It supports calcium balance in the body and helps maintain strong, healthy bones over time.
Thiamin (as thiamine HCL)
Thiamin, or Vitamin B1, supports energy production by helping convert food into fuel. Found naturally in whole grains and legumes, it also plays a role in nerve function and stress support. As thiamine HCl, it is a stable and easily absorbed form.
Riboflavin (as riboflavin 5’-phosphate sodium)
Riboflavin, also known as Vitamin B2, helps the body break down carbohydrates, proteins, and fats to produce energy. As riboflavin 5’-phosphate sodium, it’s a highly bioavailable form that also contributes to healthy skin, vision, and nervous system function.
Niacin (as niacinamide)
Niacin, or Vitamin B3, helps convert food into energy and supports skin, nerve, and digestive system health. In its niacinamide form, it is gentler on the skin and body while still offering the full range of benefits including stress support and heart health.
Vitamin B6 (as pyridoxine HCl)
Vitamin B6 plays an important role in brain development and function, as well as in the production of mood-regulating neurotransmitters. As pyridoxine HCl, it’s easily absorbed and supports immune health, metabolism, and hormone balance.
Vitamin B12 (as methylcobalamin)
Vitamin B12 is a crucial nutrient that supports energy production, red blood cell formation, and nervous system health. In its methylcobalamin form, it’s a naturally occurring and highly absorbable version that helps maintain mental clarity, mood balance, and long-term cognitive function. Because B12 is primarily found in animal products, supplementation is especially beneficial for those on plant-based diets.
Biotin
Biotin, also known as Vitamin B7, is a key nutrient for maintaining healthy hair, skin, and nails. It also supports metabolic function by helping the body convert food into energy. Biotin is often used in beauty-focused supplements for its visible benefits.
Calcium
Calcium is the most abundant mineral in the body and is crucial for maintaining strong bones and teeth. It also plays a role in muscle function, heart rhythm regulation, and nerve signaling. Adequate calcium intake is vital at all stages of life.
Iron
Iron is an essential mineral that supports the production of hemoglobin, the protein in red blood cells that carries oxygen throughout the body. It helps combat fatigue and supports energy levels, brain function, and immune response.
Organic Spirulina Powder
Nutrient-rich algae that supports energy, immunity, and detox.
Organic Alfalfa Leaf Powder
Green superfood for digestion, detox, and overall vitality.
Organic Chlorella Cracked Cell Wall Powder
Chlorophyll-rich algae that supports detox and immune health.
Organic Wheat Grass Powder
Alkalizing greens for digestion, energy, and wellness.
Horsetail Whole Herb Powder
Natural silica for healthy hair, skin, nails, and joints.
Organic Goji Fruit Powder
Antioxidant-rich berry for immunity and skin health.
Parsley Leaf Powder
Supports digestion, freshens breath, and promotes kidney health.
Papaya Fruit Powder
Natural enzymes to aid digestion and nutrient absorption.
Beet Root Powder
Supports circulation, endurance, and heart health.
Organic Broccoli Sprout Powder
Rich in sulforaphane for detox and cellular health.
Pumpkin Seed Powder
Plant protein and minerals for heart, prostate, and vitality.
Organic Barley Grass Powder
Chlorophyll-packed greens for digestion and detox.
Spinach Whole Plant Powder
Nutrient-dense greens for bone, heart, and overall health.
Cabbage Leaf Powder
Cruciferous vegetable for digestion and detox support.
Acai Fruit Extract
Antioxidant superfruit for skin, heart, and vitality.
Blueberry Fruit Powder
Brain, heart, and healthy-aging support.
Organic Maitake Mushroom Fruiting Body Powder
Adaptogenic mushroom for immunity and energy.
Quercetin
Plant antioxidant for immune and heart health.
Apple Powder (pectin)
Soluble fiber for digestion and gut health.
Probiotic Blend
Healthy bacteria for gut, digestion, and immune support.
Amylase
Digestive enzyme for breaking down carbohydrates.
Peptidase
Helps break down peptides into smaller amino acids for better protein utilization.
Alpha-Galactosidase
Supports digestion of complex carbohydrates, particularly from beans and legumes.
Glucoamylase
Assists in breaking down starch into glucose for energy.
Cellulase
Aids in digesting plant fiber (cellulose) to support nutrient absorption.
Pectinase
Helps break down pectin from fruits and vegetables, supporting smoother digestion.
Protease
Breaks down proteins into amino acids for muscle and tissue support.
Lipase
Supports fat digestion by breaking down dietary fats into fatty acids.
Lactase
Aids in the digestion of lactose (milk sugar) for those sensitive to dairy.
Beta-Glucanase
Assists in breaking down beta-glucans from grains and yeast.
Invertase
Helps convert sucrose into simpler sugars for easier utilization.
Hemicellulase
Aids in digesting plant fibers (hemicellulose), supporting gut comfort.
Artichoke Extract (leaf)
Traditionally used to support healthy digestion and liver function.
Fennel Powder (seed)
Known for soothing digestive discomfort and supporting gut health.
Fructo-oligosaccharides (FOS)
Prebiotic fibers that nourish beneficial gut bacteria.
Organic Reishi Mushroom Fruiting Body Powder
Adaptogen for stress, immune, and longevity.
Organic Cordyceps Mycelium Powder
Supports energy, endurance, and oxygen use.
Licorice Root Extract
A traditional herbal supplement that supports digestive comfort, respiratory health, and stress balance.
Ashwagandha Root Powder
An adaptogenic herb that helps support stress relief, energy, and overall well-being.
Organic Hericium erinaceus (Lion’s Mane) Mycelial Biomass & Fruiting Body Powder
A functional mushroom known for supporting focus, memory, and nerve health.
Bacopa (Leaf, Stem, Root, Flower & Seed) Extract
A traditional herb used to support memory, clarity, and stress resilience.
Milk Thistle Seed Extract
Antioxidant herb for liver and detox support.
Burdock Root Extract
Promotes skin, digestion, and natural detox.
Dandelion Root Extract
Supports liver, digestion, and detoxification.
Coenzyme Q10 (as ubidecarenone)
Antioxidant for heart and cellular energy.
Garlic Root Extract
Supports circulation, heart, and immune health.
Grape Seed Extract
Antioxidant for skin elasticity and cardiovascular function.
Chinese Hawthorn Leaf Extract
Supports healthy circulation and heart function.
Pantethine
Vitamin B5 form for energy metabolism and cholesterol balance.
Organic Turmeric Rhizome Powder
Anti-inflammatory for joints, brain, and overall health.





